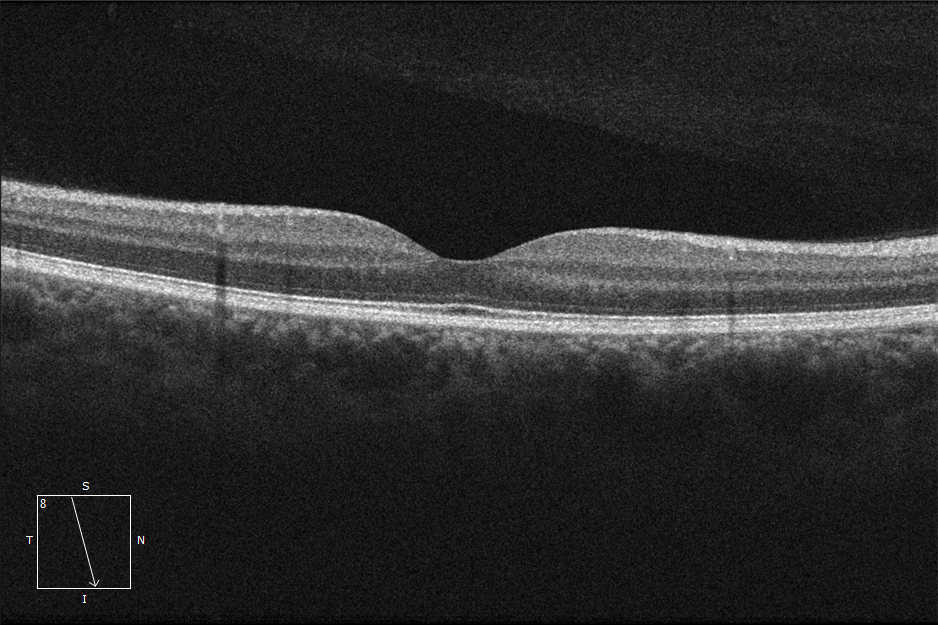

Curso taller educación médica en retinopatía diabética
Enseñanza de oftalmoscopía indirecta con el Dr. Pedro Iván Velasco Fuentes En el marco del curso-taller de Educación Médica en Retinopatía Diabética (25 de octubre),...
Publicaciones sobre retinopatía diabética, OCT, angiografía, cirugía de retina, catarata, glaucoma y síntomas visuales que no deben ignorarse.
Información educativa escrita desde la experiencia clínica.

Enseñanza de oftalmoscopía indirecta con el Dr. Pedro Iván Velasco Fuentes En el marco del curso-taller de Educación Médica en Retinopatía Diabética (25 de octubre),...

Taller práctico: Oftalmoscopia directa e indirecta (con láser) En el marco del curso-taller de Educación Médica en Retinopatía Diabética (25 de octubre, UAEMéx —...

Participación del Dr. José Gilberto Islas de la Vega — Ultrasonido Ocular Modo B en vivo En el marco del curso-taller de Educación Médica en Retinopatía Diabética (25...

Curso-Taller de Educación Médica en Retinopatía Diabética — 25 de octubre de 2025 El 25 de octubre de 2025 realizamos el curso-taller Educación Médica en Retinopatía...

Nuestros estudios de diagnóstico en la Clínica de Microcirugía Ocular En CMO usamos un enfoque multimodal para evaluar enfermedad de retina, nervio óptico y córnea....
OCT de mácula normal (corte radial 3D): interpretación capa por capa y valor clínico Imagen: Corte radial de mácula de alta definición (B-scan) con reconstrucción...

Nervio óptico normal en 3D con OCT (ZEISS CIRRUS HD-OCT 5000) ¿Qué estamos viendo? La figura muestra una reconstrucción tridimensional (3D) del disco óptico obtenida...

La luz que guía cada recuperación: homenaje a las enfermeras en oftalmología En el mundo hospitalario oftalmológico hay una luz que orienta cada tratamiento y...

Dentro de un quirófano de retina: así trabaja el equipo y la tecnología que cuidan tu visión La imagen muestra una cirugía de retina en progreso dentro de un...

De Jena al quirófano: una experiencia de innovación y visión de futuro 👁️🔬 Recientemente, el Dr. Monares visitó personalmente las instalaciones de Zeiss en Jena,...
El blog orienta, pero una valoración permite revisar tu caso con exploración y estudios adecuados.
Recibe por correo cada nueva publicación. Puedes darte de baja cuando quieras.